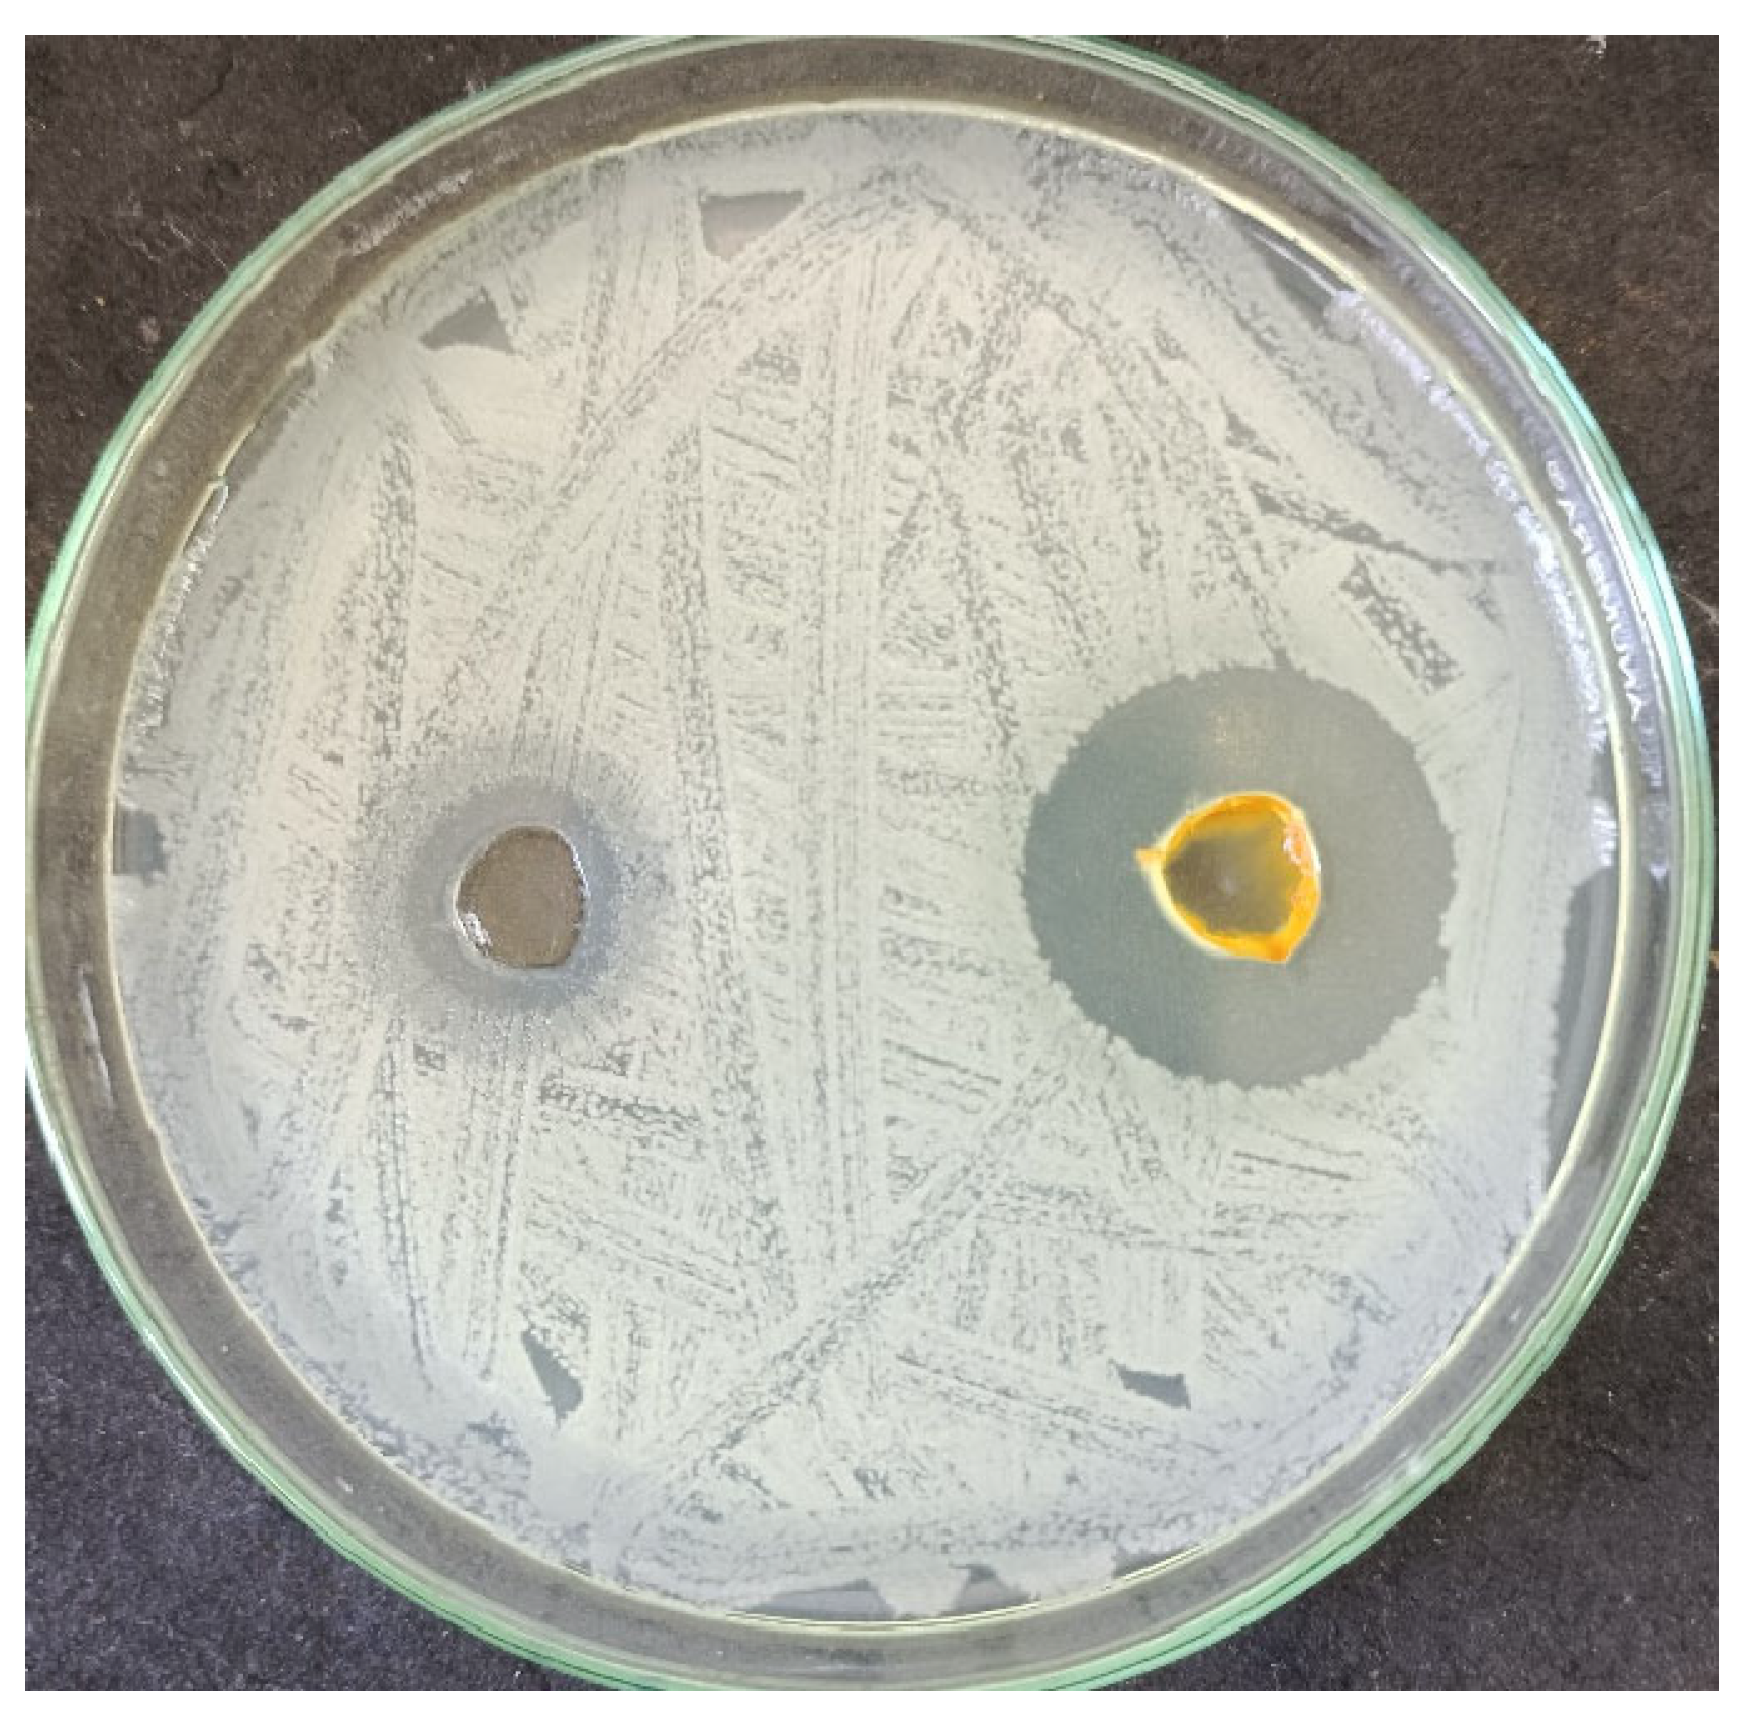
Inorganics 12 00189 g011
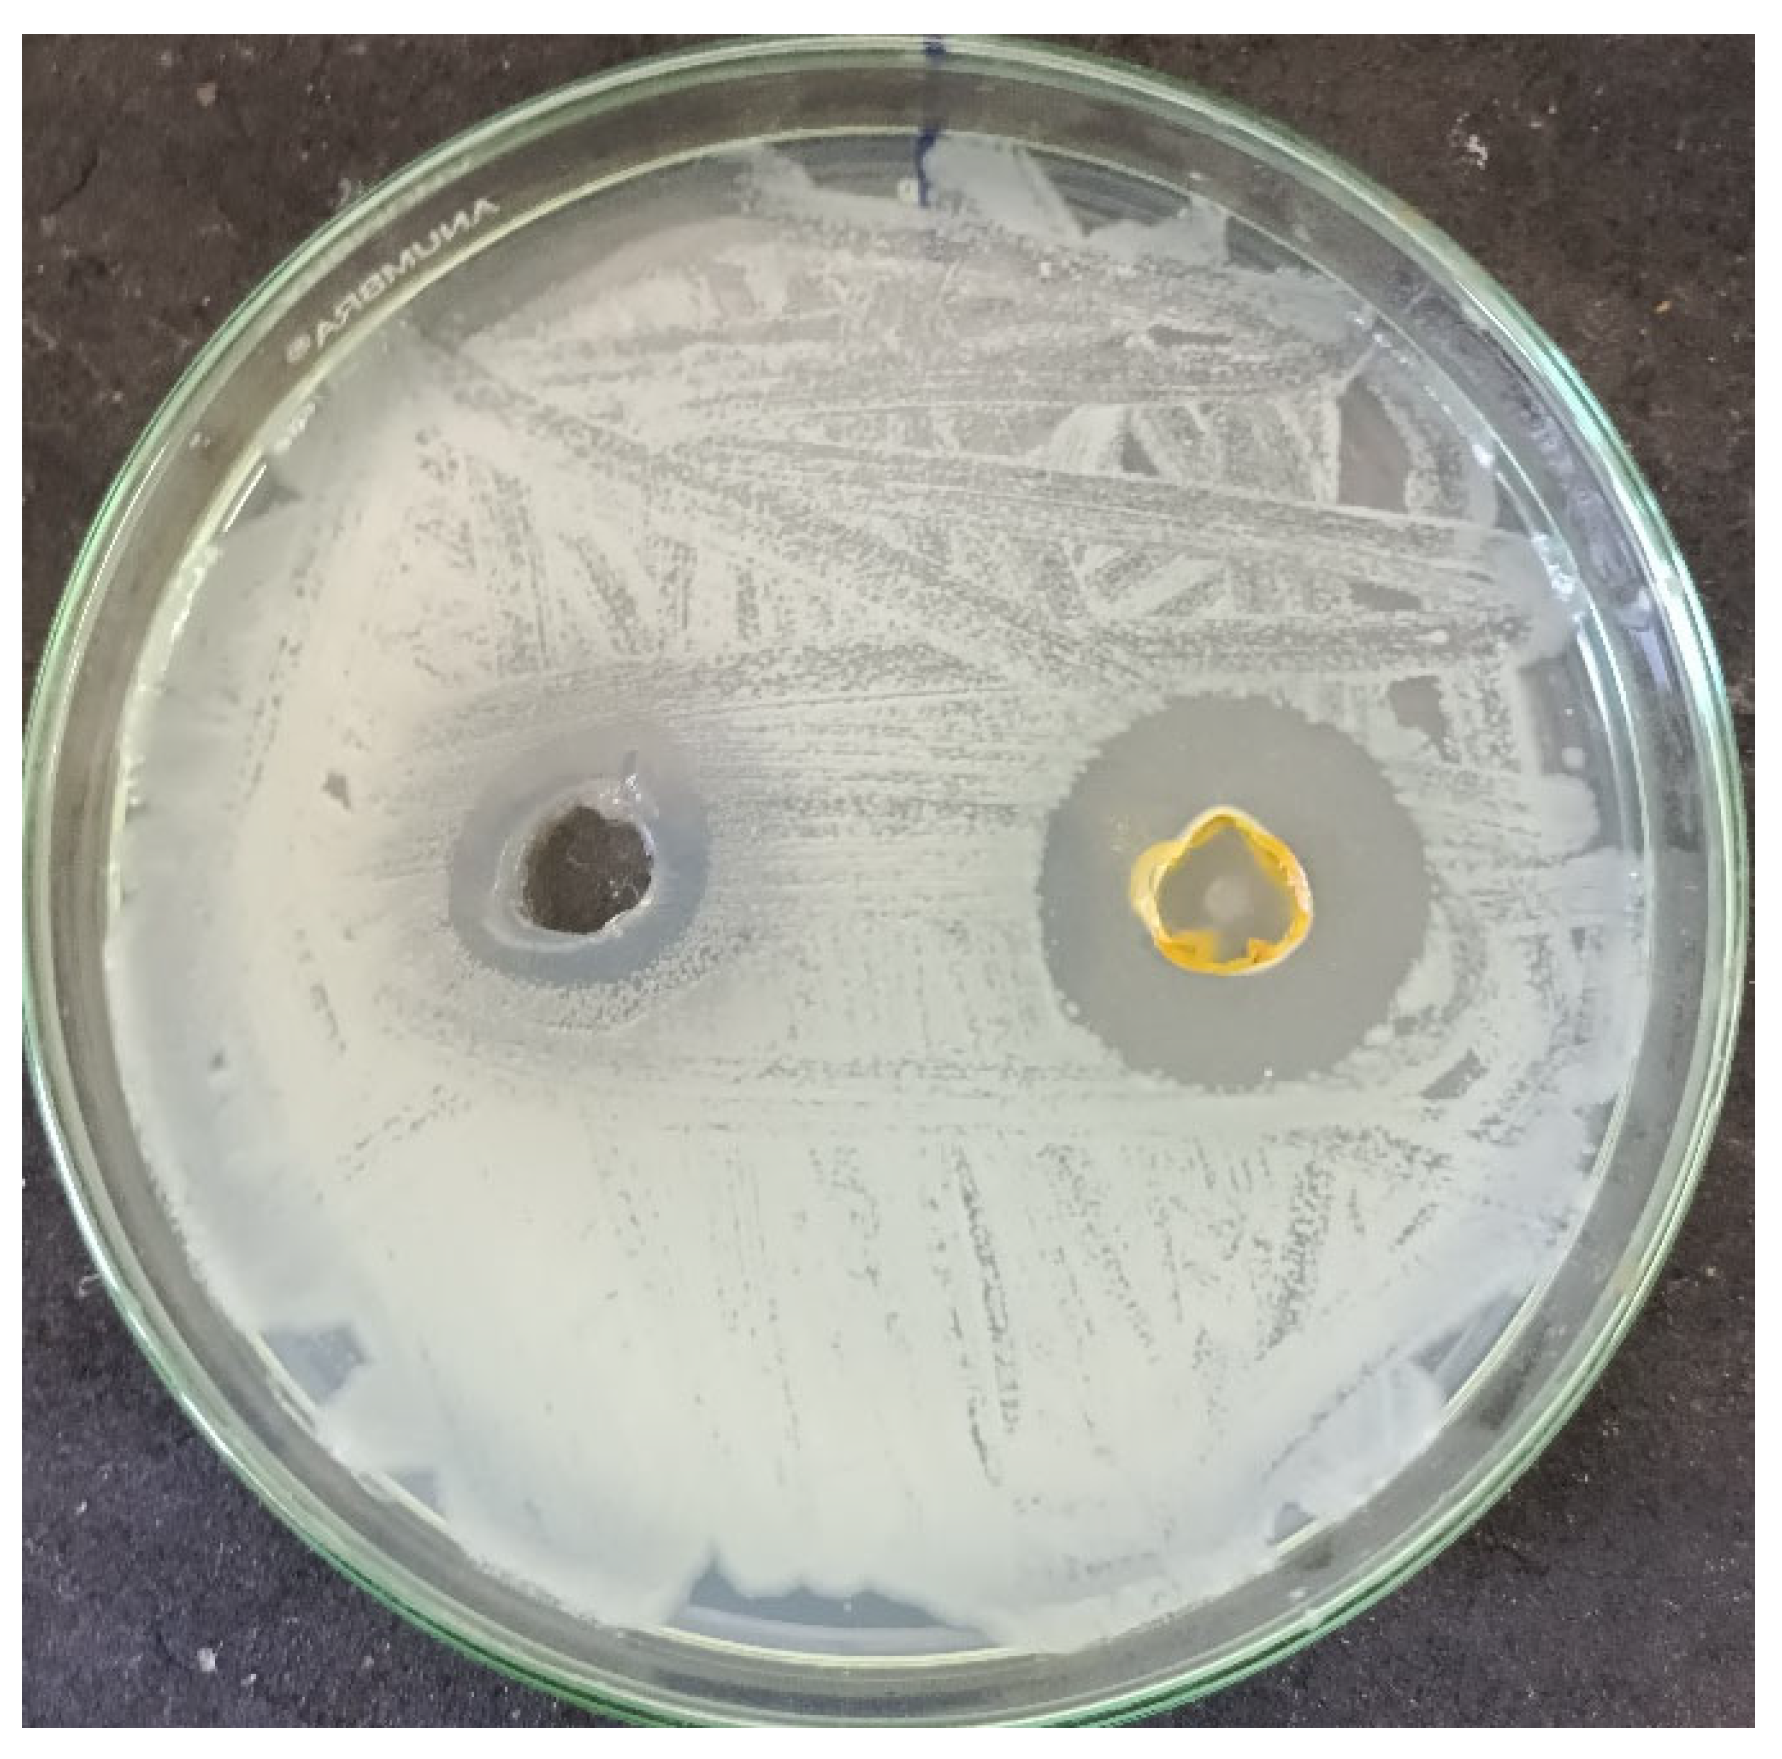
Inorganics 12 00189 g012
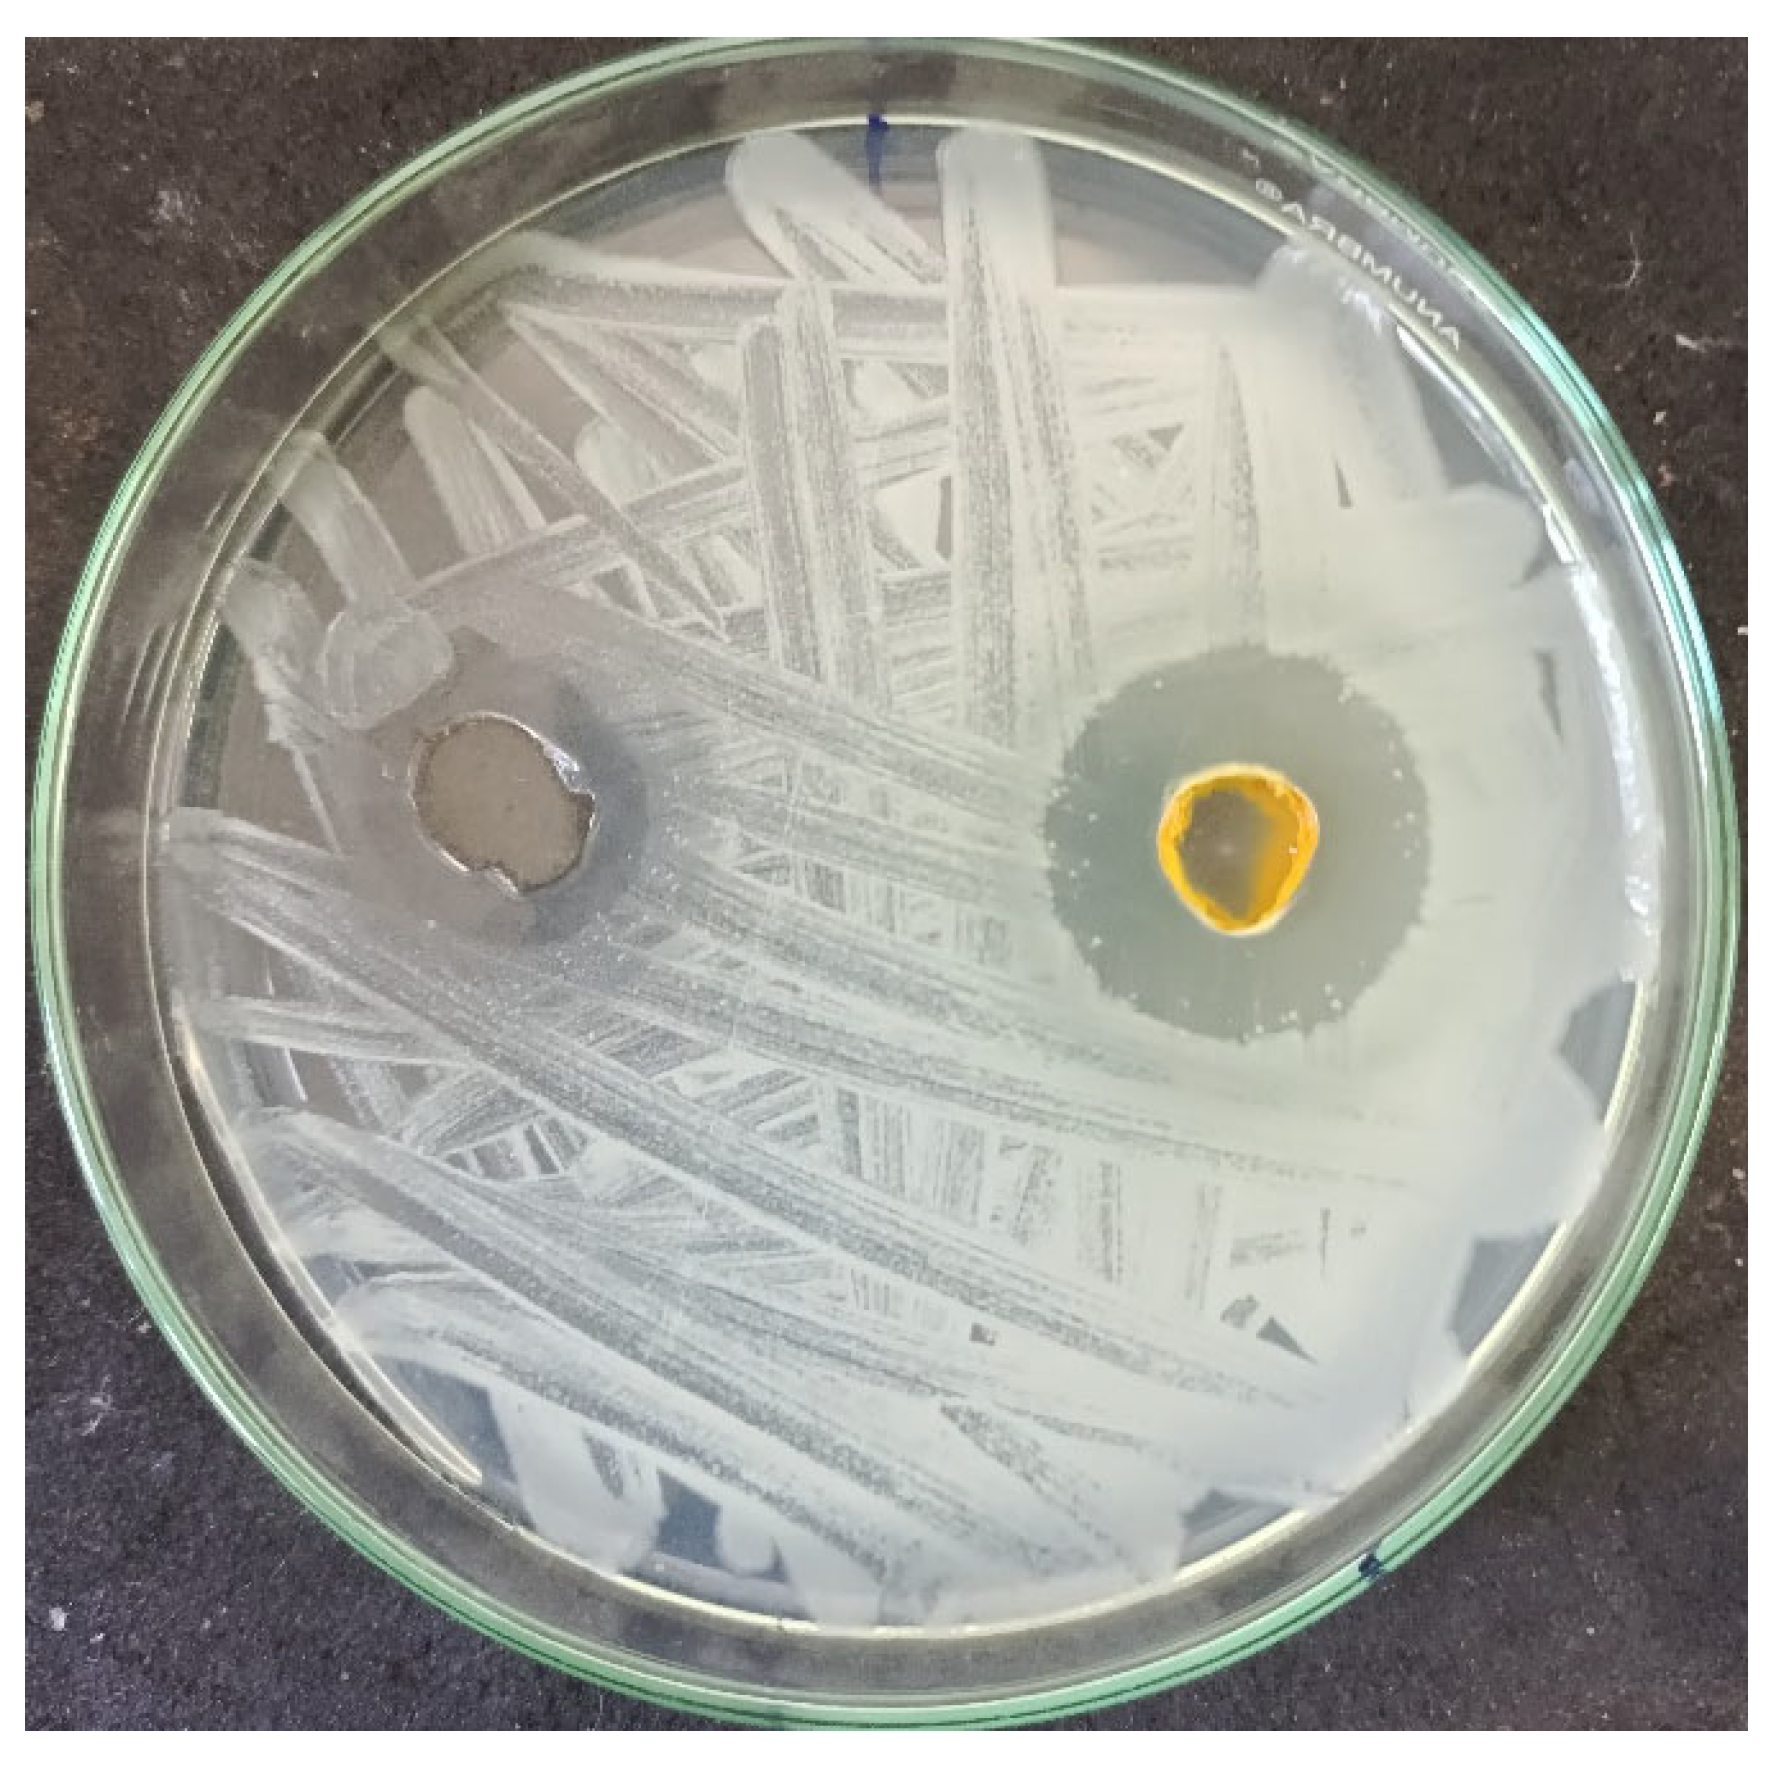
Inorganics 12 00189 g013

Synthesis, Characterization, DNA, Fluorescence, Molecular Docking, and Antimicrobial Evaluation of Novel Pd(II) Complex Containing O, S Donor Schiff Base Ligand and Azole Derivative
Abstract
1. Introduction
2. Results and Discussion
2.1. FT-IR Spectral Studies
2.2. UV–Vis Absorption and Fluorescence Spectra
2.3. Thermal Analysis of [Pd(HMBATSC)(2-ABZ)H2O] Compound
2.4. XRD Analysis of the Palladium(II) Compound
2.5. Antimicrobial Activity
2.6. DNA Binding Studies
2.6.1. UV–Vis Spectral Study
2.6.2. Fluorescence Studies
2.6.3. Viscosity Studies
2.7. Computational Study of Ligands L2H2 and Deprotonated L22−
2.8. Computational Study of Ligand L1
2.9. Computational Study of Palladium(II) Complex
2.10. TDDFT Results
3. Experimental
3.1. Materials
3.2. Physical Measurements
3.3. Synthesis of HMBATSC Ligand
3.4. Synthesis of [Pd(HMBATSC)(2-ABZ)H2O] Complex
3.5. Antimicrobial Activity
3.5.1. Antibacterial Investigation
3.5.2. DNA-Binding Studies
3.5.3. Viscosity Measurements
3.5.4. Theoretical Procedures
4. Conclusions
Supplementary Materials
Author Contributions
Funding
Data Availability Statement
Acknowledgments
Conflicts of Interest
References
- Kovala-Demertzi, D.; Boccarelli, A.; Demertzis, M.; Coluccia, M. In vitro antitumor activity of 2-acetyl pyridine 4N-ethyl thiosemicarbazone and its platinum(II) and palladium(II) complexes. Chemotherapy 2007, 53, 148–152. [Google Scholar] [CrossRef] [PubMed]
- Gulerman, N.N.; Rollas, S.; Erdeniz, H.; Kiraj, M. Antibacterial, Antifungal and Antimycobacterial Activities of Some Substituted Thiosemicarbazides and 2,5-Disubstituted-1,3,4-Thiadiazoles. J. Pharm. Sci. 2001, 26, 1. [Google Scholar]
- Tarasconi, P.; Albertini, R.; Bonati, A.; Dall Aglio, P.P.; Lunghi, P.; Pinelli, S. Synthesis, Spectroscopic Characterization and Biological Properties of New Natural Aldehydes Thiosemicarbazones. Bioinorg. Med. Chem. 2000, 8, 154–162. [Google Scholar] [CrossRef] [PubMed]
- Wang, M.; Wang, L.F.; Li, Y.Z.; Li, Q.X.; Xu, Z.D.; Qu, D.Q. Antitumour activity of transition metal complexes with the thiosemicarbazone derived from 3-acetylumbelliferone. Transit. Met. Chem. 2001, 26, 307–310. [Google Scholar] [CrossRef]
- Reddy, B.K.; Reddy, K.J.; Kumar, J.R.; Kumar, A.K.; Reddy, A.V. Highly sensitive extractive spectrophotometric determination of palladium (II) in synthetic mixtures and hydrogenation catalysts using benzildithiosemicarbazone. Anal. Sci. 2004, 20, 925–930. [Google Scholar] [CrossRef]
- Ramesh, M.; Chandrasekar, K.B.; Reddy, K.H. Spectrophotometric determination of lead (II) in water samples using benzil α-monoxime isonicotinoyl hydrazone. Indian J. Chem. 2000, 9A, 1337–1339. [Google Scholar]
- Sree Devi, R.; Kumari, S.S. Synthesis, Characterization and Antimicrobial Studies of Metal Complexes from 2-Hydroxy-3-Methoxy Benzaldehyde and L-Serine. Int. J. Eng. Res. Technol. 2020, 9, 371–375. [Google Scholar] [CrossRef]
- Annapoorani, S.; Krishnan, C. Synthesis and spectroscopic studies of trinuclear N4 Schiff base complexes. Int. J. Chem. Tech. Res. 2013, 5, 180–185. [Google Scholar]
- Ibrahim, A.B.; Al-Fakeh, M.S.; Fathy, A.; Elkhalik, S.A.; Villinger, A.; Abbas, S. Antimony Complexes with SNN Thiosemicarbazones: Synthesis, Structural Studies and Cytotoxicity against Bacterial and Cancer Cells. J. Mol. Struct. 2024, 1313, 138704. [Google Scholar] [CrossRef]
- Hossain, A.M.S.; Méndez-Arriaga, J.M.; Gómez-Ruiz, S.; Xie, J.; Gregory, D.H.; Akitsu, T.; Ibragimov, A.B.; Sun, B.; Xia, C. Review on metal complexes with 4N-methyl (thiosemicarbazone). Polyhedron 2023, 244, 116576. [Google Scholar] [CrossRef]
- Oliveira, C.G.; Romero-Canelón, I.; Silva, M.M.; Coverdale, J.P.C.; Maia, P.I.S.; Batista, A.A.; Castelli, S.; Desideri, A.; Sadler, P.J.; Deflon, V.M. Palladium(ii) complexes with thiosemicarbazones derived from pyrene as topoisomerase IB inhibitors. Dalton Trans. 2019, 48, 16509–16517. [Google Scholar] [CrossRef] [PubMed]
- Li, M.; Yu, Y.; Liu, J.; Chen, Z.; Cao, S. Investigation of the interaction between benzaldehyde thiosemicarbazone compounds and xanthine oxidase. J. Mol. Struct. 2018, 1159, 23–32. [Google Scholar] [CrossRef]
- Swaminathan, J.; Anbusrinivasan, P.; Vijayalakshmi, A. Synthesis, geometrical, spectral and anti bacterial studies of 4-hydroxy-3-methoxybenzaldehyde thiosemicarbazone by experimental and theoretical investigations. Comput. Theor. Chem. 2023, 1229, 114338. [Google Scholar] [CrossRef]
- Maged, S. Al-Fakeh, Synthesis and Characterization of Coordination Polymers of 1,3-Di(4-Pyridyl)-Propane And 2-Aminobenzothiazole with Mn(II), Co(II), Cu(II) and Ni(II) Ions. J. Chem. Pharm. Res. 2018, 10, 77–83. [Google Scholar]
- Huang, G.; Cierpicki, T.; Grembecka, J. 2-Aminobenzothiazoles in anticancer drug design and discovery. Bioorganic Chem. 2023, 135, 106477. [Google Scholar] [CrossRef] [PubMed]
- Abdellatif, K.R.A.; Belal, A.; El-Saadi, M.T.; Amin, N.H.; Said, E.G.; Hemeda, L.R. Design, synthesis, molecular docking and antiproliferative activity of some novel benzothiazole derivatives targeting EGFR/HER2 and TS. Bioorganic Chem. 2020, 101, 103976. [Google Scholar] [CrossRef] [PubMed]
- Al-Fakeh, M.S.; Alsikhan, M.A.; Alnawmasi, J.S. Physico-Chemical Study of Mn(II), Co(II), Cu(II), Cr(III), and Pd(II) Complexes with Schiff-Base and Aminopyrimidyl Derivatives and Anti-Cancer, Antioxidant, Antimicrobial Applications. Molecules 2023, 28, 2555. [Google Scholar] [CrossRef] [PubMed]
- Al-Fakeh, M.; Amiri, N.; Al-Hakemi, A.N.; El-Sayed Saeed, S.; Albadri, A.E.A.E. Synthesis and properties of two Fe (III) coordination polymers based on 2-amino-4-methylthiazole, 2-mercaptobenzothiazole and aromatic polycarboxylate. Asian J. Chem. 2020, 32, 2502–2506. [Google Scholar] [CrossRef]
- Suganthy, P.K.; Prabhu, R.N.; Sridevi, V.S. Palladium (II) thiosemicarbazone complex: Synthesis, structure and application to carbon–oxygen cross-coupling reaction. Inorg. Chem. Commun. 2014, 44, 67–69. [Google Scholar] [CrossRef]
- Sirajuddin, M.; Ali, S.; Badshah, A. Drug-DNA interactions and their study by UV-Visible, fluorescence spectroscopies and cyclic voltametry. J. Photochem. Photobiol. B 2013, 124, 1–19. [Google Scholar] [CrossRef]
- Galindo-Murillo, R.; Cheatham, T.E. Ethidium bromide interactions with DNA: An exploration of a classic DNA-ligand complex with unbiased molecular dynamics simulations. Nucleic Acids Res. 2021, 49, 3735–3747. [Google Scholar] [CrossRef]
- Ali, R.; Alminderej, F.M.; Messaoudi, S.; Saleh, S.M. Ratiometric ultrasensitive optical chemisensor film based antibiotic drug for Al(III) and Cu(II) detection. Talanta 2021, 221, 121412. [Google Scholar] [CrossRef] [PubMed]
- Praveen Kumar, A.; Mohan Reddy, K.P.P.R.; Veera Reddy, T.; Raveendra Reddy, P.; Krishna Reddy, V. Synthesis and characterisation of 2-hydroxy-3-methoxy benzaldehyde thiosemicarbazone (HMBATSC) and its application of simultaneous second order derivative spectrophotometric method for determination of cobalt(II), nickel(II) and vanadium(V). Main Group Chem. 2006, 5, 141–151. [Google Scholar] [CrossRef]
- Kalasi, P.S. Spectroscopy of Organic Compounds; New Age International Publications Ltd.: New Delhi, India, 1995. [Google Scholar]
- Aly, A.A.M.; Ghandour, M.; Alfakeh, M.S. Synthesis and characterization of transition metal coordination polymers derived from 1,4-benzenedicarboxylate and certain azoles. Turk. J. Chem. 2012, 36, 69–79. [Google Scholar] [CrossRef]
- Al-Hazmy, S.M.; Zouaghi, M.O.; Al-Johani, J.N.; Arfaoui, Y.; Al-Ashwal, R.; Hammami, B.; Alhagri, I.A.; Alhemiary, N.A.; Hamdi, N. Chemosensing Properties of Coumarin Derivatives: Promising Agents with Diverse Pharmacological Properties, Docking and DFT Investigation. Molecules 2022, 27, 5921. [Google Scholar] [CrossRef]
- Mnasri, A.; Mejri, A.; Al-Hazmy, S.M.; Arfaoui, Y.; Özdemir, I.; Gürbüz, N.; Hamdi, N. Silver–N-heterocyclic carbene complexes-catalyzed multicomponent reactions: Synthesis, spectroscopic characterization, density functional theory calculations, and antibacterial study. Arch. Der Pharm. 2021, 354, 2100111. [Google Scholar] [CrossRef] [PubMed]
- Abu-Shqair, I.; Diab, N.; Salim, R.; Al-Subu, M. Spectroscopic Studies on the Binding of Some Fluoroquinolones with DNA. Asian J. Appl. Sci. 2013, 1, 179–184. [Google Scholar]
- Shiri, F.; Hadidi, S.; Rahimi-Nasrabadi, M.; Ahmadi, F.; Ganjali, M.R.; Ehrlich, H. Synthesis, characterization and DNA binding studies of a new ibuprofen–platinum(II) complex. J. Biomol. Struct. Dyn. 2019, 38, 1119–1129. [Google Scholar] [CrossRef]
- Srivani, I.; Kumar, A.P.; Reddy, P.R.; Reddy, K.M.; Reddy, V.K. Synthesis of 2-Hydroxy-3-Methoxy Benzaldehyde Thiosemicarbazone (HMBATSC) and its Application for Direct and Second Derivative Spectrophotometric Determination of Palladium(II). Ann. Di Chim. 2007, 97, 1237–1245. [Google Scholar] [CrossRef]
- Wahl, P.; Paoletti, J.; Le Pecq, J.-B. Decay of Fluorescence Emission Anisotropy of the Ethidium Bromide-DNA Complex Evidence for an Internal Motion in DNA. Proc. Natl. Acad. Sci. USA 1970, 65, 417–421. [Google Scholar] [CrossRef]
- Ling, X.; Zhong, W.; Huang, Q.; Ni, K. Spectroscopic studies on the interaction of pazufloxacin with calf thymus DNA. J. Photochem. Photobiol. B Biol. 2008, 93, 172–176. [Google Scholar] [CrossRef] [PubMed]
- Sun, Y.; Bi, S.; Song, D.; Qiao, C.; Mu, D.; Zhang, H. Study on the interaction mechanism between DNA and the main active components in Scutellaria baicalensis Georgi. Sens. Actuators B Chem. 2007, 129, 799–810. [Google Scholar] [CrossRef] [PubMed]
- Heller, D.P.; Greenstock, C.L. Biophysical Chemistry Fluorescence lifetime analysis of DNA intercalated ethidium bromide and quenching by free dye. Biophys. Chem. 1994, 50, 305–312. [Google Scholar] [CrossRef] [PubMed]
- Khajeh, M.A.; Dehghan, G.; Dastmalchi, S.; Shaghaghi, M.; Iranshahi, M. Spectroscopic profiling and computational study of the binding of tschimgine: A natural monoterpene derivative, with calf thymus DNA. Spectrochim. Acta Part A Mol. Biomol. Spectrosc. 2018, 192, 384–392. [Google Scholar] [CrossRef] [PubMed]
- Kumar, C.; Turner, R.; Asuncion, E. Groove binding of a styrylcyanine dye to the DNA double helix: The salt effect. J. Photochem. Photobiol. A Chem. 1993, 74, 231–238. [Google Scholar] [CrossRef]
- Frisch, M.J.; Trucks, G.W.; Schlegel, H.B.; Scuseria, G.E.; Robb, M.A.; Cheeseman, J.R.; Montgomery, J.A., Jr.; Vreven, T.K.K.N.; Kudin, K.N.; Burant, J.C.; et al. Gaussian 09, Revision D.01; Gaussian, Inc.: Wallingford, CT, USA, 2013. [Google Scholar]
- Shahabadi, N.; Akhtarshenas, S.; Hadidi, S. Synthesis, characterization and DNA interaction studies of new copper complex containing pseudoephedrine hydrochloride drug. Nucleosides Nucleotides Nucleic Acids 2019, 38, 680–699. [Google Scholar] [CrossRef]
- Alotayeq, A.; Ghannay, S.; Alhagri, I.A.; Ahmed, I.; Hammami, B.; Albadri, A.E.A.E.; Patel, H.; Messaoudi, S.; Kadri, A.; Al-Hazmy, S.M.; et al. Synthesis, optical properties, DNA, β-cyclodextrin interaction, hydrogen isotope sensor and computational study of new enantiopure isoxazolidine derivative (ISoXD). Heliyon 2024, 10, e26341. [Google Scholar] [CrossRef]
- Gaber, M.; El-Wakiel, N.A.; El-Ghamry, H.; Fathalla, S.K. Synthesis, spectroscopic characterization, DNA interaction and biological activities of Mn(II), Co(II), Ni(II) and Cu(II) complexes with [(1H-1,2,4-triazole-3-ylimino)methyl]naphthalene-2-ol. J. Mol. Struct. 2014, 1076, 251–261. [Google Scholar] [CrossRef]
- GaussView, Version 5; Semichem Inc.: Shawnee Mission, KS, USA, 2009.
- Becke, A.D.J. Density-Functional Thermochemistry. III. The Role of Exact Exchange. Chem. Phys. 1993, 98, 5648–5652. [Google Scholar] [CrossRef]
- Lee, C.; Yang, W.; Parr, R.G. Development of the Colle-Salvetti Correlation-Energy Formula into a Functional of the Electron Density. Phys. Rev. B 1988, 37, 785–789. [Google Scholar] [CrossRef]

| Parameters | Pd(II) Complex |
|---|---|
| F.W | C16H20N5S2PdO4 516.83 |
| Crystal System | Monoclinic |
| a (Å) | 17.92 |
| b (Å) | 15.99 |
| c (Å) | 9.89 |
| Alfa (°) | 90.00 |
| Beta (°) | 90.00 |
| Gamma (°) | 90.00 |
| Particle Size (nm) | 18.7 |
| V.U.C (Å3) | 2836 |
| Sample Name | Clear Zone (mm) | |||
|---|---|---|---|---|
| S. aureus | E. coli | C. albicans | A. niger | |
| Pd(II) complex | 28 | 27 | 26 | 28 |
| Neomycin | 31 | 25 | 29 | 0 |
| Cyclohexamide | 0 | 0 | 0 | 36 |
| Complex | ΔEgas (kcal/mol) | ΔEsolv Ethanol (kcal/mol) |
|---|---|---|
| Pd(L2)(NL1) | 0 | 0 |
| Pd(L2)(NH2L1) | 6.1 | 7.5 |
| Pd(L2)(SL1) | 17.5 | 16.9 |
| Complex | Transition | λ (nm) | Oscillator Strength |
|---|---|---|---|
| L2H2 | HOMO → LUMO | 326.8 | 0.2939 |
| L1 | HOMO → LUMO | 247.1 | 0.2445 |
| Pd(L2)(NL1) | HOMO → LUMO | 736.3 | 0.0304 |
Disclaimer/Publisher’s Note: The statements, opinions and data contained in all publications are solely those of the individual author(s) and contributor(s) and not of MDPI and/or the editor(s). MDPI and/or the editor(s) disclaim responsibility for any injury to people or property resulting from any ideas, methods, instructions or products referred to in the content. |
© 2024 by the authors. Licensee MDPI, Basel, Switzerland. This article is an open access article distributed under the terms and conditions of the Creative Commons Attribution (CC BY) license (https://creativecommons.org/licenses/by/4.0/).
Share and Cite
Al-Fakeh, M.S.; Alrasheedi, M.; Mohammed, A.E.M.E.; Ibrahim, A.B.M.; Al-Hazmy, S.M.; Alhagri, I.A.; Messaoudi, S. Synthesis, Characterization, DNA, Fluorescence, Molecular Docking, and Antimicrobial Evaluation of Novel Pd(II) Complex Containing O, S Donor Schiff Base Ligand and Azole Derivative. Inorganics 2024, 12, 189. https://doi.org/10.3390/inorganics12070189
Al-Fakeh MS, Alrasheedi M, Mohammed AEME, Ibrahim ABM, Al-Hazmy SM, Alhagri IA, Messaoudi S. Synthesis, Characterization, DNA, Fluorescence, Molecular Docking, and Antimicrobial Evaluation of Novel Pd(II) Complex Containing O, S Donor Schiff Base Ligand and Azole Derivative. Inorganics. 2024; 12(7):189. https://doi.org/10.3390/inorganics12070189
Chicago/Turabian StyleAl-Fakeh, Maged S., Muneera Alrasheedi, Ard Elshifa M. E. Mohammed, Ahmed B. M. Ibrahim, Sadeq M. Al-Hazmy, Ibrahim A. Alhagri, and Sabri Messaoudi. 2024. "Synthesis, Characterization, DNA, Fluorescence, Molecular Docking, and Antimicrobial Evaluation of Novel Pd(II) Complex Containing O, S Donor Schiff Base Ligand and Azole Derivative" Inorganics 12, no. 7: 189. https://doi.org/10.3390/inorganics12070189
APA StyleAl-Fakeh, M. S., Alrasheedi, M., Mohammed, A. E. M. E., Ibrahim, A. B. M., Al-Hazmy, S. M., Alhagri, I. A., & Messaoudi, S. (2024). Synthesis, Characterization, DNA, Fluorescence, Molecular Docking, and Antimicrobial Evaluation of Novel Pd(II) Complex Containing O, S Donor Schiff Base Ligand and Azole Derivative. Inorganics, 12(7), 189. https://doi.org/10.3390/inorganics12070189

